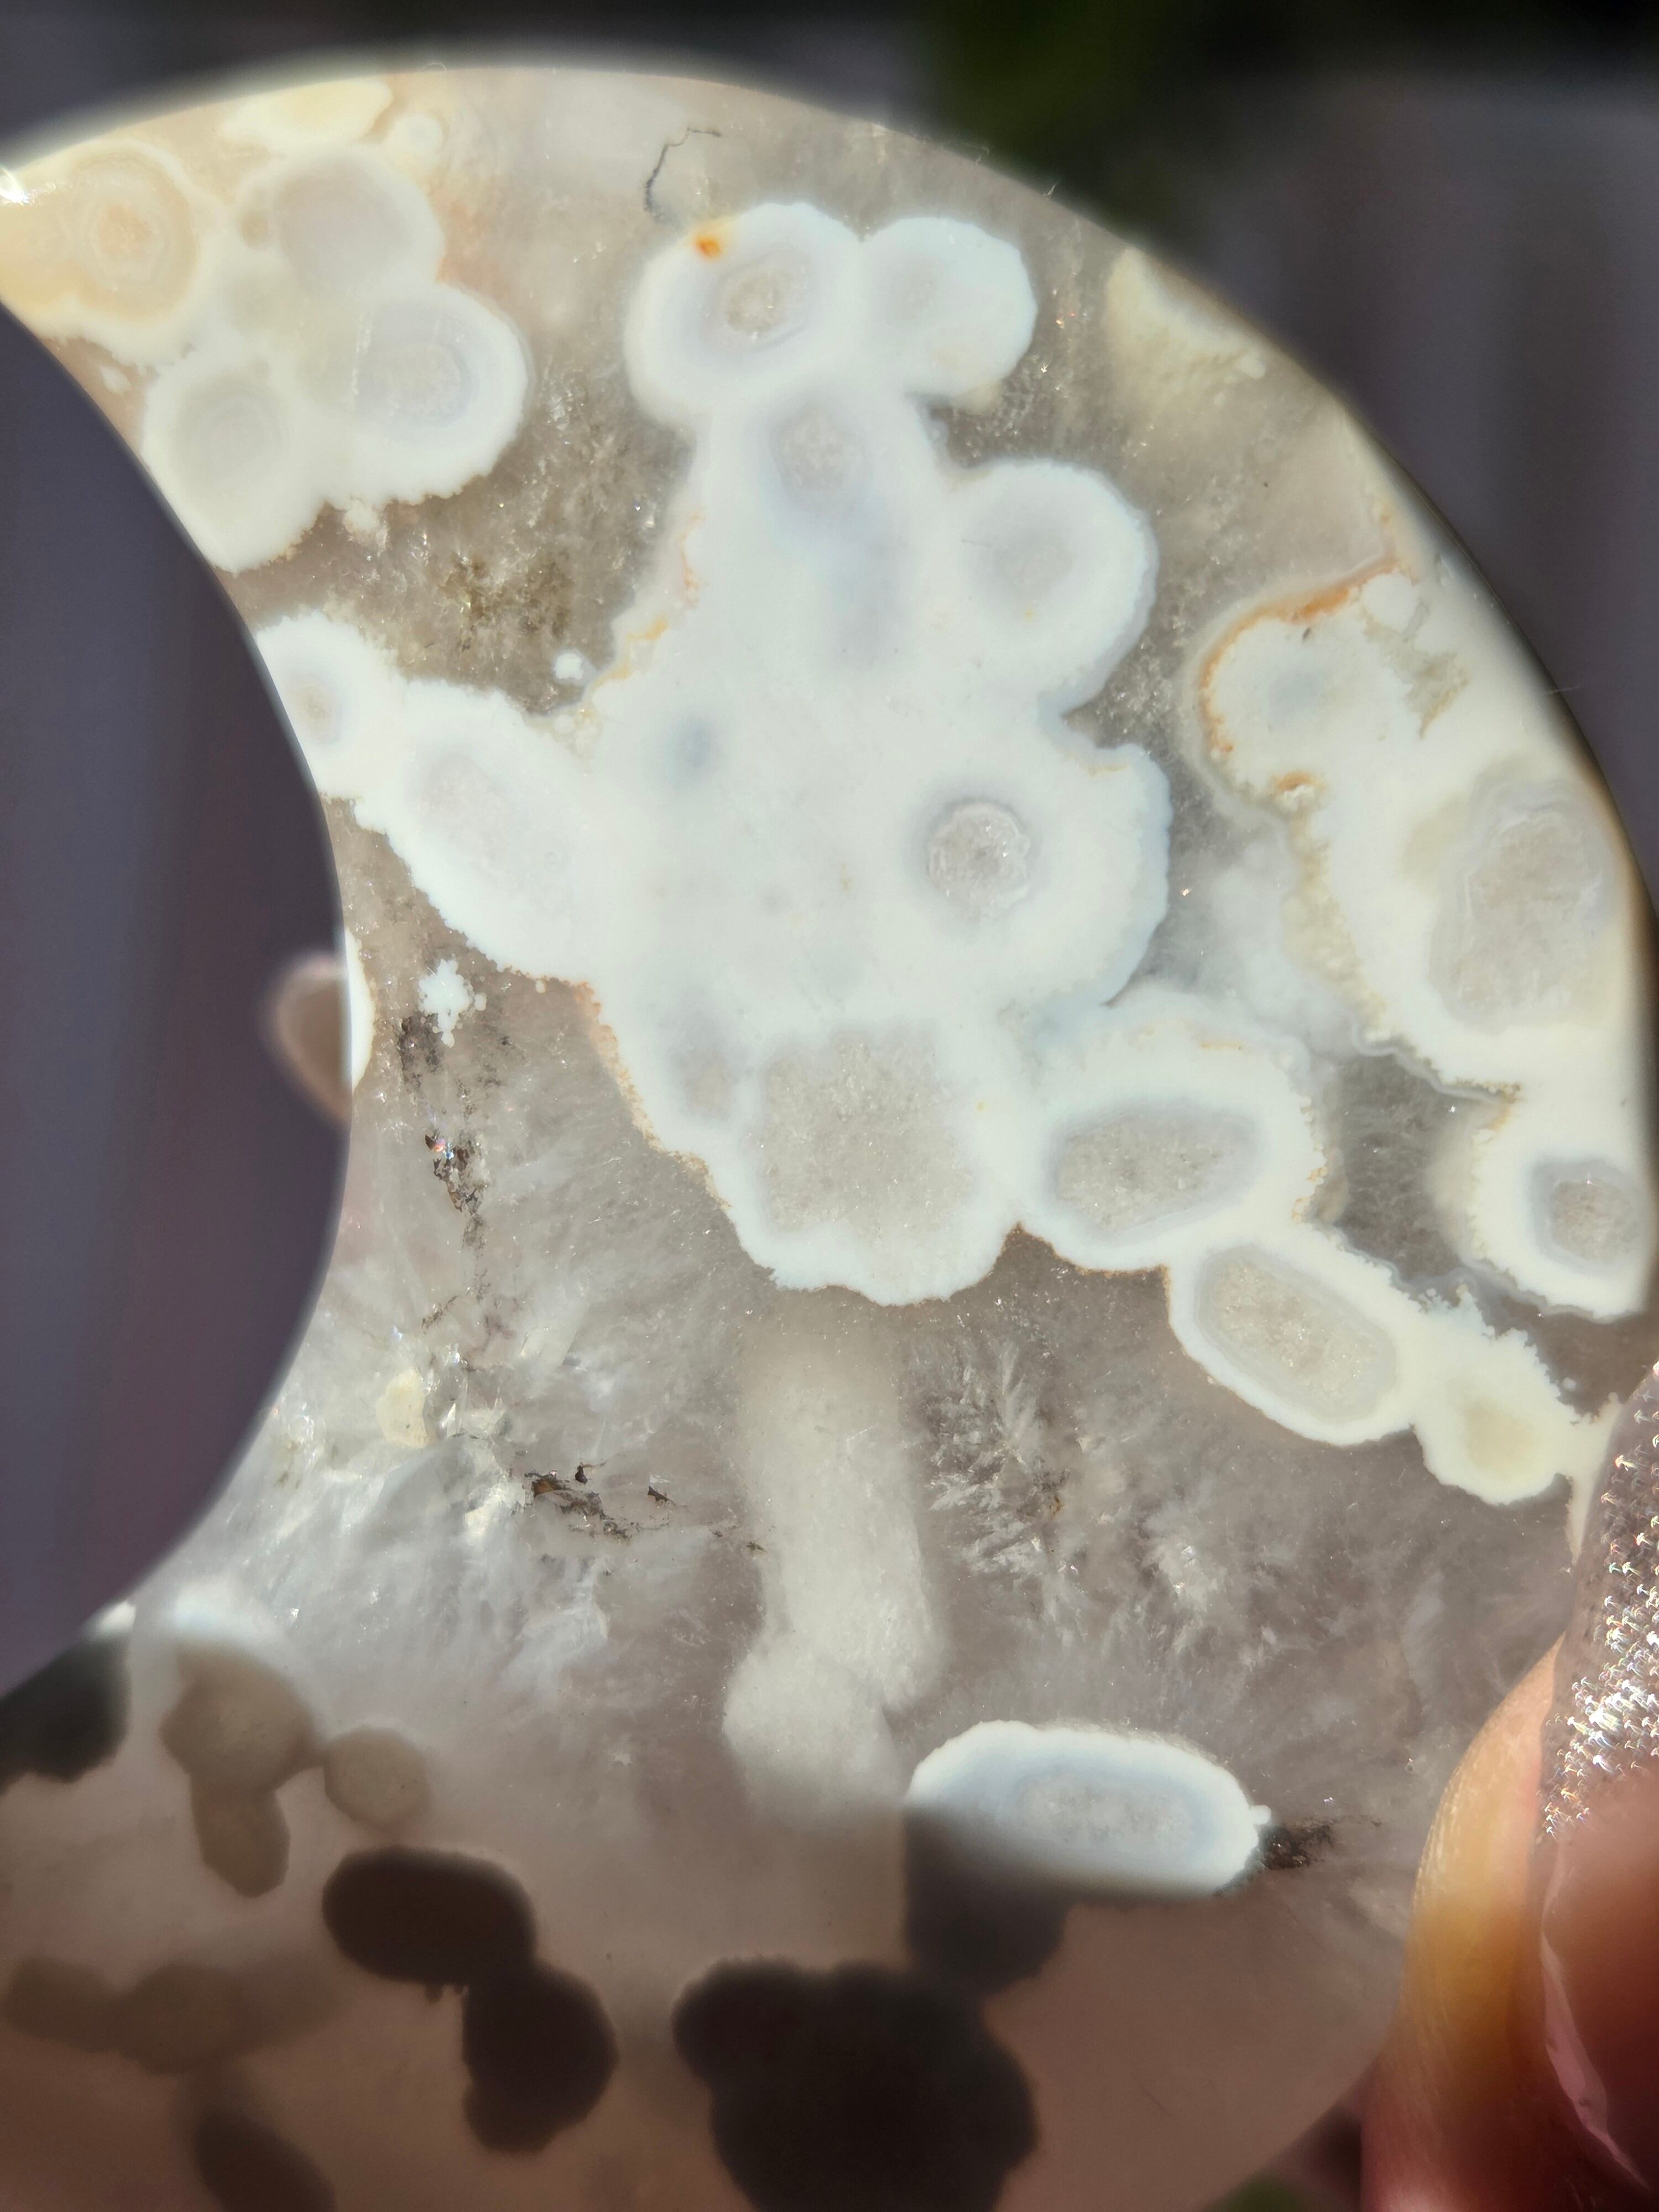

1/19
フラワーアゲートムーンパーム
¥1,800
残り1点
International shipping available
フラワーアゲートのムーン形パームになります。
透明感あるクォーツにお花模様が可愛らしいです。
ザクザクのジオード部分もオススメポイントです。
フラワーアゲートは持ち主をリラックスさせ、心身ともにエネルギーを満たしてくれる効果があると言われています。 心と身体の調和を保つ効果があることから体調を整え、ストレスや不安などのマイナスエネルギーを解消してくれると言われています。 また、古くからお守りとしても用いられてきており、邪気除けの効果があると信じられてきました。
size:56.3mm×46mm×11.8mm
-
レビュー
(554)
最近チェックした商品
同じカテゴリの商品
セール中の商品
その他の商品